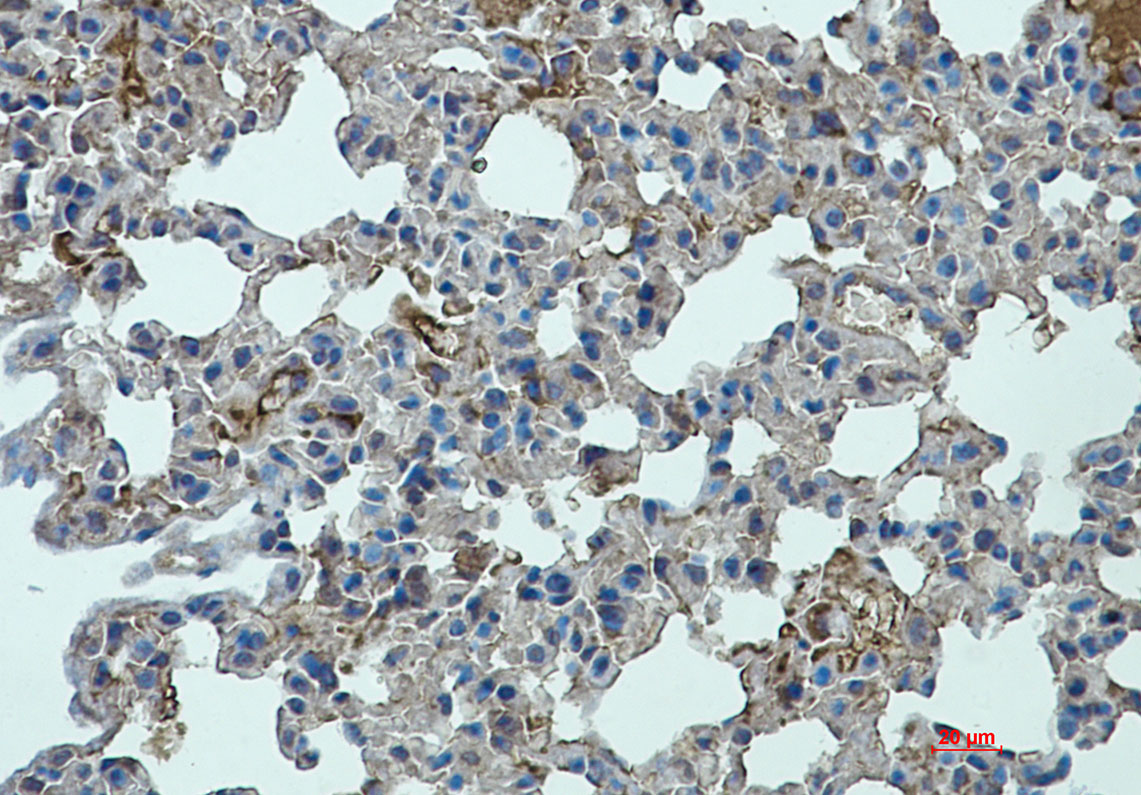

-
分类: 科研抗体货号: P22583别名: 100 kDa NT receptor; Glycoprotein 95; Gp95; LDLCQ6; Neurotensin receptor 3; NT3; NTR3; SORT 1; Sortilin 1应用: WB,IHC反应种属: Human,Rat
-
分类: 科研抗体货号: P22582别名: SNX1; Sorting nexin-1应用: WB,IHC,IF反应种属: Human
-
分类: 科研抗体货号: P22598别名: TCP1; CCT1; CCTA; T-complex protein 1 subunit alpha; TCP-1-alpha; CCT-alpha应用: WB,IP,IHC,IF反应种属: Human,Hamster
-
分类: 科研抗体货号: P22581别名: CSS11; Rsc6p; BAF60A; CRACD1应用: WB,IP反应种属: Human
-
分类: 科研抗体货号: P22587别名: STAT4; Signal transducer and activator of transcription 4应用: WB,IP,IHC反应种属: Human
-
分类: 科研抗体货号: P22597别名: TBP; GTF2D1; TF2D; TFIID; TATA-box-binding protein; TATA sequence-binding protein; TATA-binding factor; TATA-box factor; Transcription initiation factor TFIID TBP subunit应用: WB,IP,IHC,IF反应种属: Human,Mouse
-
分类: 科研抗体货号: P22580别名: SMARCA2; BAF190B; BRM; SNF2A; SNF2L2; Probable global transcription activator SNF2L2; ATP-dependent helicase SMARCA2; BRG1-associated factor 190B; BAF190B; Protein brahma homolog; hBRM; SNF2-alpha; SWI/SNF-related matrix-associated actin-dependent regulat应用: WB,IHC,IF反应种属: Human
-
分类: 科研抗体货号: P22586别名: AW496480; 1600010G07Rik应用: WB,IHC反应种属: Human,Mouse
-
分类: 科研抗体货号: P22596别名: PSK2; TAO1; KFC-B; MARKK; PSK-2; hKFC-B; hTAOK1; MAP3K16应用: WB,IP反应种属: Human,Mouse,Rat
-
分类: 科研抗体货号: P22579别名: SMAD4; DPC4; MADH4; Mothers against decapentaplegic homolog 4; MAD homolog 4; Mothers against DPP homolog 4; Deletion target in pancreatic carcinoma 4; SMAD family member 4; SMAD 4; Smad4; hSMAD4应用: WB,IP,IF反应种属: Human,Rat

鄂公网安备42018502007531号
鄂公网安备42018502007531号

